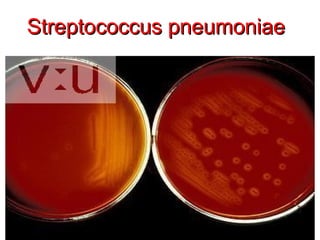
Streptococcus pneumoniae




11/26/12   Dr.T.V.Rao MD   17
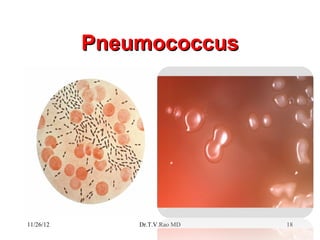
Pneumococcus




11/26/12       Dr.T.V.Rao MD   18
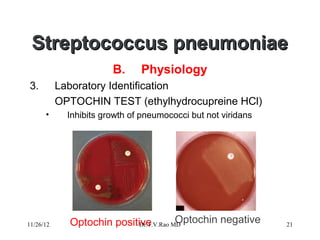
Streptococcus pneumoniae
                        B.     Physiology
3.         Laboratory Identification
           OPTOCHIN TEST (ethylhydrocupreine HCl)
      •      Inhibits growth of pneumococci but not viridans




11/26/12     Optochin positive          Optochin negative
                            Dr.T.V.Rao MD                      21

Streptococcus pneumoniae, commonly known as pneumococcus, is a Gram-positive bacterium that is a major cause of pneumonia. It has over 90 known serotypes and uses an antiphagocytic polysaccharide capsule as a main virulence factor. Identification methods include culture characteristics such as being optochin positive and bile soluble as well as serological tests like the Quellung reaction.